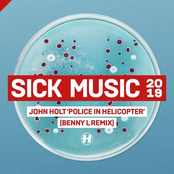
Police In Helicopter (Benny L Remix)

Loading details…
Artist
John Holt
about
John Kenneth Holt (born 11 July 1947 in Kingston, Jamaica; died 19 October 2014 in London, England) was a reggae singer and songwriter who first found fame as a member of the Paragons before establishing himself as a solo artist. Amongst the songs he wrote was "The Tide Is High" (later made famous by Blondie and also covered by Atomic Kitten). On an island renowned for its superb vocalists and composers, John Holt remains head and shoulders above the rest as one of Jamaica's sweetest singers and enduring songwriters. He voiced and penned so many of the country's classics that in a way, Holt defined the island's sound. Born in the Greenwich Farm area of Kingston, Jamaica, on July 11, 1947, the young Holt took his first steps into the music business via the talent show circuit. Talent shows have always had a massive popularity in Jamaica and the top ones were initially broadcast live on radio and later on television. Many of the island's greatest artists (Gregory Isaacs amongst them) made their first appearances in talent shows, and it has proved an excellent training ground for young hopefuls. In 1958, the 12-year-old Holt entered his first contest, run by promoter Joseph Verejohn. Over the next four years, the youngster became a staple of these shows, notching up a record-breaking 28 titles. His dulcet tones were soon familiar to a much larger audience, as a number of these contests were broadcasts of Radio Jamaica. For his final victory in 1962, Holt performed Solomon Bur
top songs
albums

Police In Helicopter

Help Me Make It Through The Night: The Best Of John Holt

Like a Bolt (Expanded Version)

The Best Of John Holt

2000 Volts Of Holt

1000 Volts of Holt

1000 Volts of Holt (Deluxe Edition)

The Prime of John Holt: 20 Massive Recordings From 1970-1976

Memories By The Score Vol. 2
Police In Helicopter (Benny L Remix)

His-Story

The Tide Is High
